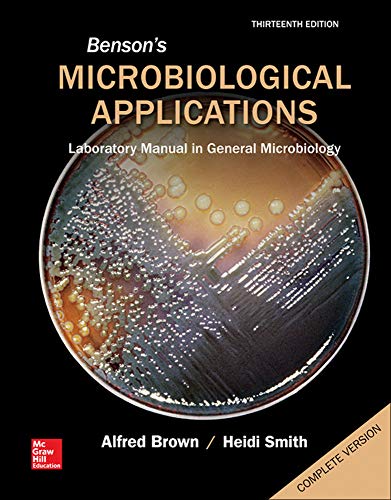

Benson's Microbiological Applications: Laboratory Manual in General Microbiology, Complete Version
Regular price
$99.48 USD
Regular price
Sale price
$99.48 USD
Unit price
per
Shipping calculated at checkout.
Couldn't load pickup availability
Benson's Microbiological Applications: Laboratory Manual in General Microbiology, Complete Version | ATX Book Store
ISBN: 0077668022
Publisher: McGraw-Hill Education
Product details
- Publisher
- McGraw-Hill Education
- Publication date
- January 3, 2014
- ISBN-10
- 0077668022
- ISBN-13
- 9780077668020
- Item Weight
- 40.8 oz
- Dimensions
- in